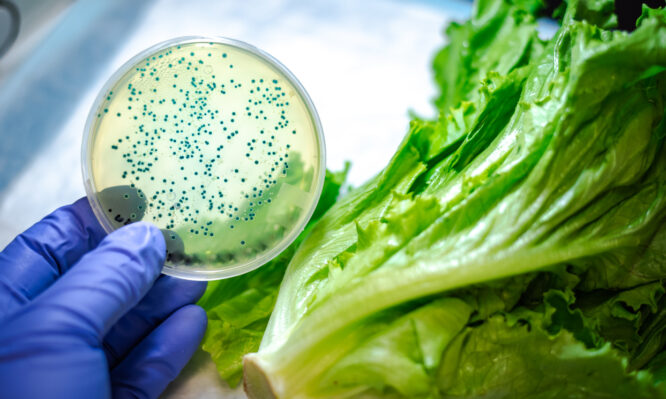
σαλμονέλα

Σαλμονέλα: Πάνω από 1.000 άνθρωποι αρρώστησαν το 2024 στην Ελλάδα
Από το 2005 είχε να καταγραφεί τετραψήφιος αριθμός κρουσμάτων στη χώρα μας.
Από το 2005 είχε να καταγραφεί τετραψήφιος αριθμός κρουσμάτων στη χώρα μας.

Σε πόση θερμοκρασία πρέπει να βράζει ο κρόκος και για πόση ώρα για να εξουδετερώνονται τυχόν παθογόνα.

Τι ανακάλυψαν οι επιστήμονες για την επίδραση της υγρασίας στην επιβίωση του βακτηρίου στα νωπά τρόφιμα.

Πόσα κρούσματα καταγράφονται ετησίως και ποια χαρακτηριστικά συμπτώματα προκαλεί.

Η απίστευτη περίπτωση μιας γυναίκας που υπέφερε επί 18 χρόνια και γλίτωσε τελευταία στιγμή την σήψη.

Τι αποκαλύπτει νέα έκθεση του ECDC. Πόσα κρούσματα καταγράφονται στην Ευρωπαϊκή Ένωση.

Σε τι θερμοκρασία και για πόση ώρα πρέπει να μαγειρεύεται το φαγητό για να προστατευθούμε από τη σαλμονέλα.

Τι ανακοίνωσε ο ΕΟΔΥ με αφορμή δύο ανάλογες συρροές κρουσμάτων στην Ευρώπη. Πόσο να ανησυχούμε.

Τι συνιστούν τα CDC και ο ΕΦΕΤ. Πως μπορεί να μολυνθούν από βακτήρια τα αυγά. Πρακτικές συμβουλές ασφαλείας.

Όλοι γνωρίζουν ότι τα αυγά περιέχουν σαλμονέλα, ένα επικίνδυνο βακτήριο που εξουδετερώνεται μόνο όταν τα μαγειρεύουμε καλά.

Ποιος είναι ο κίνδυνος αν καταναλώσετε μισοψημένο κοτόπουλο. Γιατί δεν είναι πάντοτε αρκετό το ψήσιμο στον φούρνο μικροκυμάτων. Τι...

Ο υποχρεωτικός εγκλεισμός στο σπίτι εξαιτίας του νέου κορωνοϊού και οι γιορτές που πλησιάζουν έχουν ξυπνήσει σε πολλούς από...

Η λοίμωξη από το βακτήριο της σαλμονέλας (Salmonella) είναι μια κοινή βακτηριακή ασθένεια που επηρεάζει την εντερική οδό. Τα...